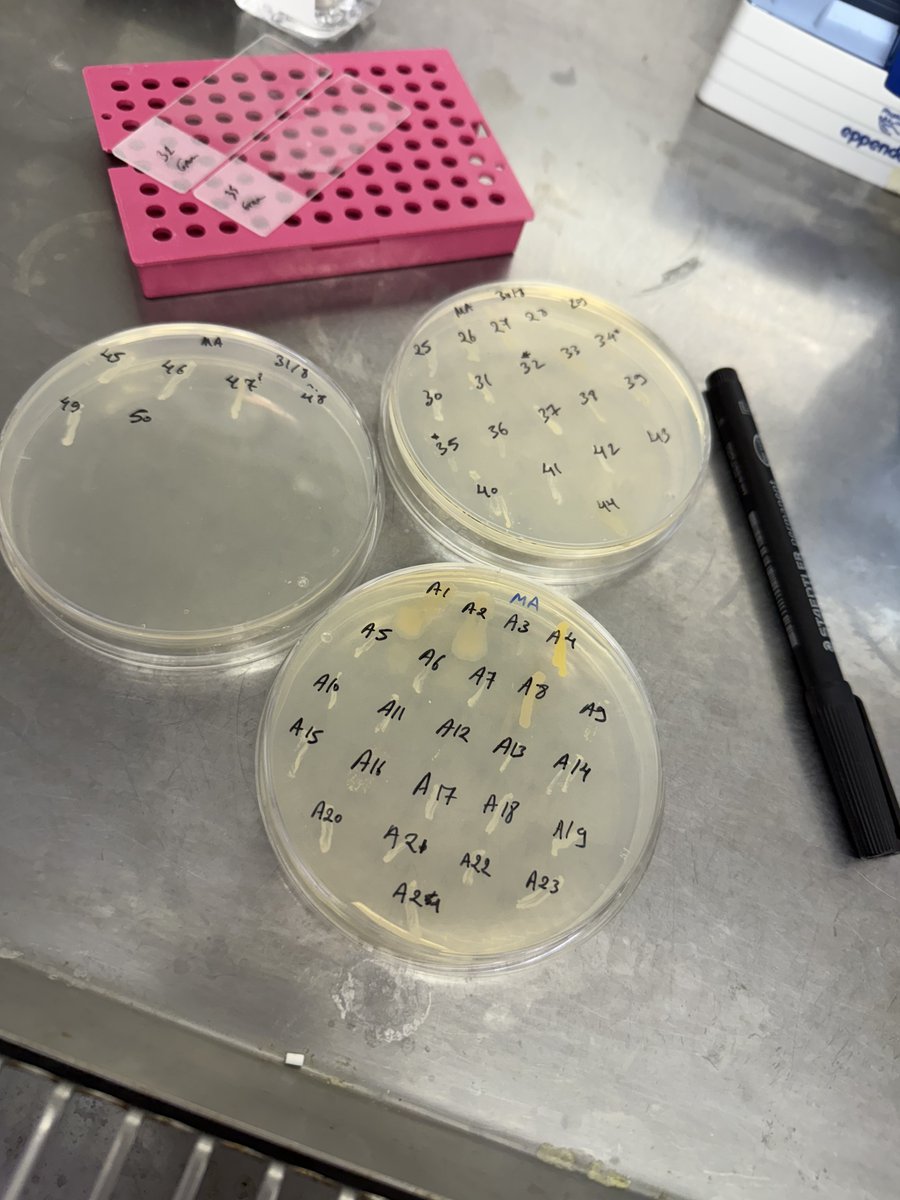

SeaSim
@seasim_aims
The National Sea Simulator - a world class experimental marine research facility at the Australian Institute of Marine Science
ID: 3233038668
http://www.aims.gov.au 02-06-2015 02:33:32
1,1K Tweet
2,2K Takipçi
1,1K Takip Edilen



Our thoughts are with those affected by flooding in N. Qld. A big shout out to the Australian Institute of Marine Science team at our #Townsville HQ who are monitoring our facilities, incl. our SeaSim staff who have been ensuring continuity of critical projects. Stay safe everyone. 📸 Kurt Pappalardo





🔬 New research from Australian Institute of Marine Science & James Cook Uni shows rising temps disrupt coral-algae symbiosis. The study found: 🔹 Heat stress alters coral-algae nutritional status, affecting coral health 🔹 Gene expression changes appear before visible stress🔗Read more: bit.ly/4h7OwFh


Supporting education for future marine scientists! 🎉 SeaSim is donating urchins to James Cook Uni's Hatchery Techniques course. These urchins were used as part of RRAP research to boost the growth and survival of baby corals. Read more >> bit.ly/43wTqIA #MarineScience #SeaSim





PhD candidates Ashtyn Isaak & Holly Koch are researching how ocean acidification & high light contribute to bleaching. The experiment includes: 🧪36 tanks, 4 species, 12 treatments, 400+ samples 🧬2 corals & 2 crustose coralline algae 🔬Drivers: light, temp, & 4 levels of PCO2



🧫What do baby Crown-of-Thorns Sea stars (CoTS) eat? Before becoming aggressive coral eaters, CoTS spend ~5–6 months post-settlement grazing algae. Researchers at Australian Institute of Marine Science + James Cook Uni found they grow 38× faster on one CCA: Melyvonnea cf. madagascariensis🔗bit.ly/417JwLw

Need an advanced marine experimental research facility to conduct your research?! Soon, researchers will be able to apply for the SeaSim Access Program, which will provide merit-based, funded access to SeaSim at Australian Institute of Marine Science. Sign up to learn more > bit.ly/4iNpSdO